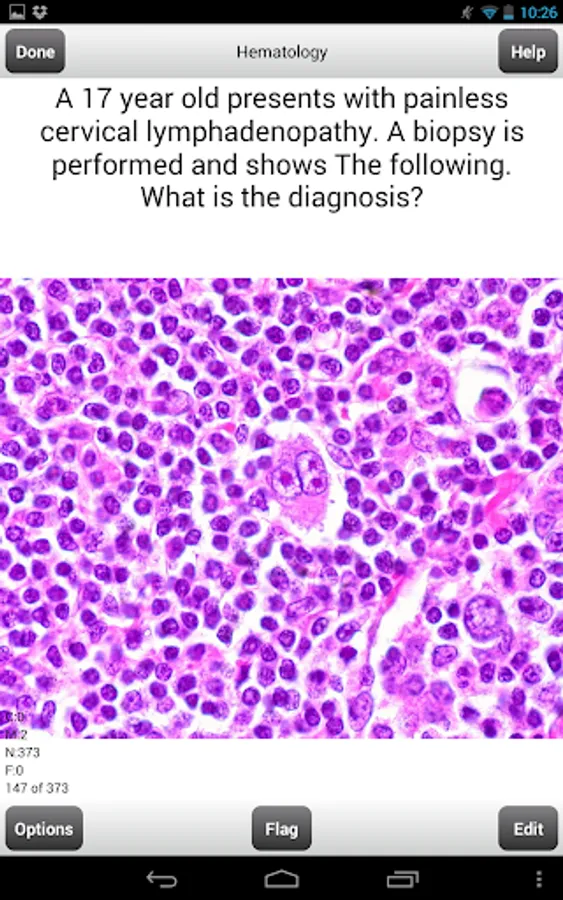

About COMLEX Level 1 Flashcards
COMLEX Level 1 Flashcards
Study for the COMLEX (Comprehensive Osteopathic Medical Licensing Examination) Level 1 with over 3000 questions that will help you master the material to do well on Level 1 of the COMLEX.
Here are the topics and flashcards included in this program:
Inflammation: 126 flashcards
Acid/Base Blood Gas:38 flashcards
Nutrition and Disease: 140 flashcards
Clotting: 134 flashcards
Cellular Changes: 48 flashcards
Cell Cycle: 62 flashcards
Cellular Injury: 118 flashcards
Fluid Shifts: 161 flashcards
Hematology: 375 flashcards
GI: 365 flashcards
Kidney: 164 flashcards
Urology: 51 flashcards
Gynecology: 125 flashcards
MSK: 98 flashcards
Skin: 31 flashcards
Neuro: 75 flashcards
Cardiology: 322 flashcards
Respiratory: 226 flashcards
Cancer: 196 flashcards
Endocrine: 205 flashcards
Total # of Questions:3060
The program itself offers various features and options for a great and convenient learning environment which include:
- Ability to Randomize cards
- Can Flag cards for later use
- Grade cards by using gestures
- Study only missed cards, only new cards, only correct cards, flagged cards, or study all cards
- Study all categories or selected categories
- Timed mode to automatically flip card and advance cards.
- Ability to edit and delete cards
- Convenient statistics panel to see progress
- Can change background color and text color
- Can change text size
- Can see back of card first
You can try out our Lite version to see the features and how to use the program.
Study for the COMLEX (Comprehensive Osteopathic Medical Licensing Examination) Level 1 with over 3000 questions that will help you master the material to do well on Level 1 of the COMLEX.
Here are the topics and flashcards included in this program:
Inflammation: 126 flashcards
Acid/Base Blood Gas:38 flashcards
Nutrition and Disease: 140 flashcards
Clotting: 134 flashcards
Cellular Changes: 48 flashcards
Cell Cycle: 62 flashcards
Cellular Injury: 118 flashcards
Fluid Shifts: 161 flashcards
Hematology: 375 flashcards
GI: 365 flashcards
Kidney: 164 flashcards
Urology: 51 flashcards
Gynecology: 125 flashcards
MSK: 98 flashcards
Skin: 31 flashcards
Neuro: 75 flashcards
Cardiology: 322 flashcards
Respiratory: 226 flashcards
Cancer: 196 flashcards
Endocrine: 205 flashcards
Total # of Questions:3060
The program itself offers various features and options for a great and convenient learning environment which include:
- Ability to Randomize cards
- Can Flag cards for later use
- Grade cards by using gestures
- Study only missed cards, only new cards, only correct cards, flagged cards, or study all cards
- Study all categories or selected categories
- Timed mode to automatically flip card and advance cards.
- Ability to edit and delete cards
- Convenient statistics panel to see progress
- Can change background color and text color
- Can change text size
- Can see back of card first
You can try out our Lite version to see the features and how to use the program.
COMLEX Level 1 Flashcards Screenshots
Tap to Rate: